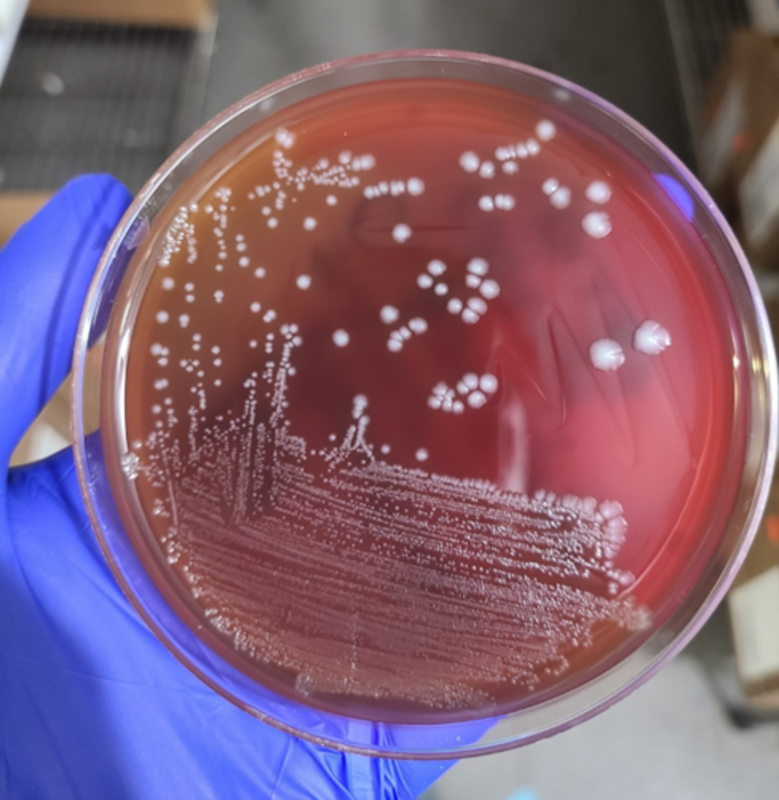

Женщина 78 лет была переведена из дома престарелых в отделение неотложной помощи из-за делирия и ухудшения состояния двусторонних хронических ран бедра с неприятным запахом.
При физикальном обследовании отмечалась лихорадка 39,5°С и гнойные выделения из раны правого бедра. Результаты анализов: лейкоциты 17,2K/mm3, гематокрит 26%, тромбоциты 694K/mm3, C-реактивный белок 9,4 мг/дл и СОЭ >130 мм/час. КТ таза и рентгеновские снимки бедер и бедренных костей показали признаки некротизирующей инфекции: дефекты мягких тканей на обоих бедрах с подкожной жидкостью, воспаление, прохождение газа вглубь бедра и неровности кортикального слоя обоих больших трохантеров.
В анаэробных флаконах двух наборов культур крови, взятых по прибытии в стационар, выросли грамположительные палочки. Колонии грамположительных палочек, выросшие на анаэробном кровяном агаре после 48 часов анаэробной инкубации, показаны на иллюстрации 1, а окраска по Граму того же организма, выросшего в приготовленном мясном бульоне, - на иллюстрациях 2А и 2В.
Иллюстрация. 1. Чашка анаэробного кровяного агара на которой растут грамположительные бациллы.

Иллюстрация 2A и 2B: Окраска по Граму мазка из мясного бульона.
Из крови были выделены грамположительные бациллы (ГПБ). Часто от ГПБ в культурах крови отмахиваются как от возможных контаминантов. Однако в условиях возможной некротизирующей инфекции мягких тканей и роста ГПБ только в анаэробных флаконах, вполне обоснованны опасения по поводу Clostridium spp. Некротизирующие инфекции мягких тканей могут быть вызваны множеством различных бактерий, но эмпирическое лечение должно надежно охватывать виды Clostridium, Streptococcus pyogenes и Staphylococcus aureus, поскольку они являются наиболее часто встречающимися патогенами. В то время как C. perfringens является распространенной причиной газовой гангрены, C. septicum часто вызывает нетравматическую газовую гангрену из-за своей аэротолерантности.
ГПБ в крови данной пациентки были идентифицированы с помощью масс-спектрометрии MALDI-ToF как C. sporogenes/botulinum группы I. Хотя C. botulinum является более знакомым патогеном, обе эти близкородственные бактерии могут продуцировать ботулинический нейротоксин (BoNT). В сравнительном геномном исследовании было обнаружено, что C. botulinum группы I обладает генами для производства BoNT A, B и/или F, в то время как C. sporogenes - только для BoNT B. Обнаружение BoNT остается сложной задачей. Кроме того, MALDI-ToF в большинстве случаев не может отличить C. botulinum от C. sporogenes из-за сходства этих двух видов.
Поскольку BoNT считается опасным биологическим агентом, необходимо соблюдать осторожность при работе с изолятами с подозрением на C. botulinum в лаборатории во время идентификации. Хотя в руководстве по сбору и транспортировке образцов Американского общества микробиологии говорится о том, что не следует пытаться культивировать организм, указывается, что клинические лаборатории могут проводить рутинное культивирование, при котором может быть выделен C. botulinum, потенциально продуцирующий BoNT.
Хотя определить наличие C. botulinum в раневых культурах может быть непросто из-за сходства грамположительных палочек с грамположительными палочками кожной флоры, лаборатории должны работать с культурами в боксах уровня биобезопасности-2 и избегать процедур, генерирующих аэрозоль (например, каталазы), чтобы свести к минимуму потенциальную аэрозолизацию токсина. Наилучшей практикой является открытая коммуникация между клиницистами и лабораторией - клиницисты должны уведомлять лабораторию о своих подозрениях. Необходимо принимать меры безопасности после лабораторных работ. Хотя в данном случае сложно провести различие между C. botulinum и C. sporogenes, необходимо было организовать правильный алгоритм действий (аналитические и постаналитические исследования), чтобы исключить/включить C. botulinum, продуцирующую BoNT.
Анализ на чувствительность к анаэробам не проводится регулярно и уместен только в отношении изолятов из стерильных источников. Во всем мире среди Clostridium spp. наблюдается рост резистентности к клиндамицину, однако метронидазол и амоксициллин-клавуланат остаются эффективными средствами для лечения Clostridium spp.
